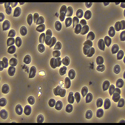
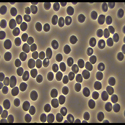
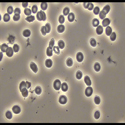
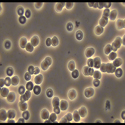
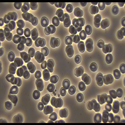
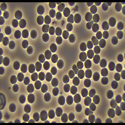
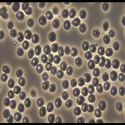

Blood Images
Images of Blood Before and After SOS Advance
Arthritis before SOS Advance |
 Arthritis after 3 bottles Advance |
 Candida Before |
Candida After 3 Bottles |
 Fatigued Before |
 Fatigued After 3 Bottles |
HIV Before |
HIV After 3 Bottles |
HIV After 6 Bottles |
HIV After 12 Bottles |
 Joint Pains before |
Joint Pains After 3 Bottles |

